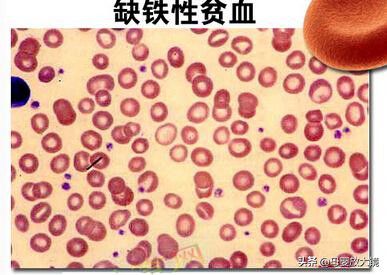
什么时候需要补硒呢(补硒需要天天补吗)-硒宝网

什么时候需要补硒呢(补硒需要天天补吗)
微量元素该补不该补?补多少才适合?什么人群在什么时候应该进补微量元素?进补微量元素时要注意什么?下面你将得到答案!
近十年来,我国城乡居民的膳食营养状况有了明显改善。但不可忽视的是,与膳食结构不合理相关的慢性非传染性疾病患病率上升迅速,如18岁以上高血压病人有1.6亿(患病率达18.8%) ;糖尿病患者有2 000多万(患病率达2.6%) ;有2亿人超重,6 000多万人肥胖,其中城市儿童肥胖率已达8.1%。与此同时,营养(特别是微量营养素)不良或缺乏仍然普遍存在。
微量营养素包括矿物元素和维生素两部分,矿物元素又分常量元素与微量元素两类。现仅就读者较为关心的几个有关微量元素的问题作一简要回答。
糖尿病患者需补铬吗
从理论上看,糖尿病患者补充铬以及锌、锰、铜、硒、镁及钙元素有助于控制病情,并且得到了一些临床应用的支持。
铬是第一个被认为与糖尿病有关的微量元素,铬是葡萄糖耐量因子的活性组分。补充铬可明显改善葡萄糖耐量、增加胰岛素活性、降低血清胆固醇。
锌通过含锌酶和蛋白参与糖和脂肪代谢,促进胰岛素原转变为有活性的胰岛素;结晶胰岛素中有0.5%成分是锌,它影响胰岛素的合成、贮存、分泌、结构完整性。缺锌易导致免疫功能低下,易得感染性疾病,会加重糖尿病的病情。
锰通过含锰酶和蛋白参与糖和脂肪代谢。实验观察到,缺锰新生豚鼠胰腺细胞先天发育不全,缺锰成年豚鼠胰腺的B细胞数量较少,导致胰岛素生成减少。
铜通过含铜酶和蛋白参与糖和脂肪代谢。实验表明,缺铜动物脂肪生成和葡萄糖氧化率下降,胰腺氧化受损而减少胰岛素的分泌。
硒通过含硒酶和蛋白的抗氧化和调节甲状腺激素作用,提高免疫力和抗病能力。近期有报道发现,硒具有类胰岛素样作用,可降低血糖。

镁能激活体内多种酶活性,调节神经肌肉活动。若干研究发现,镁缺乏使胰岛素敏感性下降,补充镁能改善胰腺B细胞反应。镁缺乏与高血压、缺血性心脏病、视网膜病变等糖尿病并发症发生有关。
钙是骨骼的主要成分,糖尿病患者常伴有钙、磷代谢紊乱,而易发生继发性骨质疏松。
另外,与糖尿病有关的元素可能还有铁、锂、钒、硼、锗、镍、钨、钼等。
补充硒可以抗癌吗

近50年来国内外对硒的生理作用做了广泛深入的研究,已充分证明硒的防病作用,具有维持正常免疫功能和抗肿瘤作用。在硒具有抗癌作用的人体流行病学干预研究中,目前报道的较有说服力的有三项。
一是1984~1990年在江苏省启东县肝癌高发区进行的6年补硒(含亚硒酸钠15毫克/千克食盐)干预试验,结果发现补硒后肝癌发病率显著下降。二是1985~1991年在河南省林县进行了近3万人的双盲干预试验,结果发现,同时补充β-胡萝卜素(15毫克)、硒酵母(50毫克硒)和维生素E(30毫克)组胃癌死亡率下降,但对食道癌无效。三是1983~1996年美国进行了为期13年的补硒(硒酵母片,含200毫克硒)双盲干预试验,受试者为1 312名有皮肤癌史的患者,结果未能得到预期阻止皮肤癌复发的效果,但发现服硒组肺癌、前列腺癌和结直肠癌的发生率显著降低。
另外,在临床肿瘤治疗中补给硒剂后,可减少化疗毒副作用,预后较好(如食欲恢复、头发生长较快)。
由于肿瘤病因的复杂性,补硒并不能预防所有癌症,如上面提到的对食道癌和皮肤癌预防效果并不理想。这些都是亟待探讨的研究课题。

女性何时需补铁
2002年调查发现,我国居民贫血患病率平均为15.2%,育龄妇女为20.6%。临床上常以全血中血红蛋白含量作为判断是否贫血的依据。我们知道血红蛋白是运送氧气的载体,当血液流经肺时,红细胞里的血红蛋白能很快抓住吸入的氧气,随血流到达各个组织器官时它又很“爽快”地放开氧气供给细胞用。血红蛋白就好比是运氧的“船”,有了足够的“船”,才能有足够的氧来维持生命。临床上的贫血就是血红蛋白减少或异常引起的。虽然有若干导致贫血的原因,不过大部分是缺铁性贫血,因为人体中2/3的铁在血红蛋白中。
女性在青春期月经来潮后,由于经血流失,血红蛋白也随之丢失,如果体内铁缺乏,就会减少血红蛋白合成而患缺铁性贫血。这也就是女性对铁的需要量高于男性的原因。由于贫血会减少氧对各细胞的供应,进而影响各组织器官功能,因此贫血对健康影响的后果是严重的。如果发现自己有倦怠、疲乏、活动后心悸、工作效率明显下降等现象,就应怀疑可能患贫血,应及时到医院检查血红蛋白含量,确定是否需要补充铁。但是,由于植物性食物中铁的吸收率较低,再加之铁的月经丢失,我们还是赞成女性额外补充一些铁,起到预防作用。
另外,孕妇处在特殊生理期,必须为自身和胎儿发育的各器官细胞供应充足的血氧;贫血孕妇的死亡率较高、早产率和胎儿死亡率也较高,而乳母则通过乳汁为婴儿提供必需的铁。因此,孕妇、乳母也需额外补充铁。

同样,我们赞成孕妇和乳母补充的不仅是铁,而且是全面的微量营养素。
“缺什么补什么”
一般来说,营养(包括微量元素)的补充原则是“缺什么补什么”。如患骨质疏松症应补充钙制剂,患缺铁性贫血应补充铁制剂。近年来,对营养的认识在更新,不只停留在满足营养需要和“不缺乏”,而强调营养应该起到促进健康、减少慢性疾病发生的作用。最新研究证明,多种维生素和矿物质的日常补充可有效预防多种慢性疾病的发生,有益于提高生活质量。
因此,为了预防疾病,不应单独补充某一种微量元素,而是多种微量元素和多种维生素一起补。目前市场上类似的微量元素和维生素补充剂(膳食补充剂)很多,只要是经过国家卫生部或食品药品监督管理局审批通过的都可以服用。但是,需要注意的是,服用了一种补充剂就不要再服用另一种类似的补充剂,因为累加起来有可能会超过耐受剂量而中毒。
由于微量元素在身体里存在的总量很少,不足人体重量的0.05%。每天的需要量在0.1克以下,所以只要我们膳食均衡不偏食,食物多样化,能经常吃水果蔬菜等,这样一日三餐就把我们所需的微量元素吃进去了,不会出现微量元素缺乏问题。
但是,有几种情况会使我们身体得不到足够的必需微量元素,就需要额外补充。第一种情况是土地中元素分布不均匀,造成同一种食物由于产地不同而所含微量元素的量不同,长期吃同一地区的食物就会造成微量元素的缺乏或过多。如氟缺乏易长龋齿,过多又会出现氟斑牙或氟骨症;硒缺乏易得克山病、大骨节病 ;碘缺乏会得大脖子甲状腺肿等,这些称为地方病。第二种情况,由于食物中其他因素影响了我们对某些必需微量元素的消化吸收。如在谷物中的铜、铁、锌、铬吸收率非常低。第三种情况,我们对微量元素的需要量与我们的身体状况有关。如儿童生长发育需要铁、钙、锌多些 ;孕妇、乳母需要铁、钙、锌多些 ;老年人需要钙、硒多些。在患某些疾病或创伤手术时,对某些微量元素的需要量也会增加(注:从营养学分类上讲,钙属于常量元素。
继续阅读
- 暂无推荐
